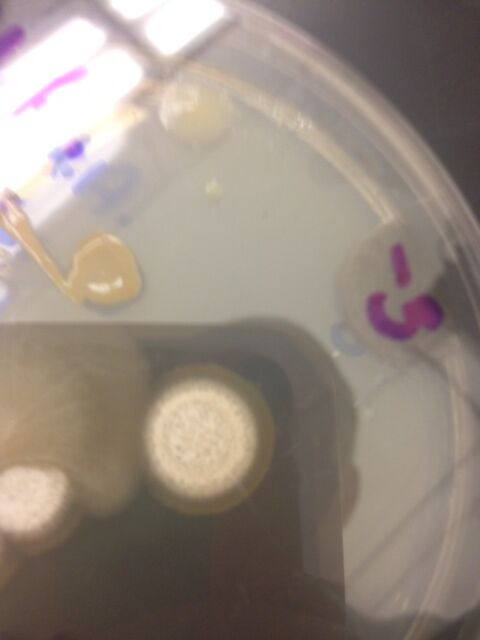

User:Aaron Weiner/Notebook/Biology 210 at AU
2/24/14
Lab 5
In this lab, we tried to determine the morphological differences between invertebrates, more specifically coelomates, pseudocoelomates, and a coelomates by observing examples of each from our transect.
Movement of Acoelomates, Pseudocoelomates, and Coelomates:
-Acoeleomates slide/glide along surfaces, almost like a slug. This could be because they completely lack a mesoderm and need to use a simpler type of movement.
-Pseudocoelomates slither along, moving their bodies side to side like a snake. These organisms have a disconnected mesoderm which could account for this slightly more advanced but relatively simplistic mode of movement.
-Coelomates move by repressing and contracting their bodies to pull/push themselves across surfaces, like a worm. These organisms are very complex and have a mesoderm, allowing them to use more complex ways of moving themselves about.
Identifying Invertebrates:
After breaking down our Berlese funnel and transferring the preservative solution to a Petri dish, we were unable to find any organisms after searching for close to 15 minutes. As such, we cannot identify any organisms or give a size range.
Animals that could live in our transect:
Garter Snake
Kingdom: Animalia
Phylum: Chordata
Subphylum: Vertebrata
Class: Reptilia
Order: Squamata
Suborder: Serpentes
Family: Colubridae
Subfamily: Natricinae
Genus: Thamnophis
Species: T. sirtalis
Could benefit from invertebrates, bird eggs, or other vertebrates to eat and loose soil to borrow into to make a nest.
Rat
Kingdom: Animalia
Phylum: Chordata
Class: Mammalia
Order: Rodentia
Superfamily: Muroidea
Family: Muridae
Subfamily: Murinae
Genus: Rattus
Species: R. norvegicus
Could benefit from invertebrates and foliage to eat and loose soil to borrow into to make a nest.
Eastern Gray Squirrel
Kingdom: Animalia
Phylum: Chordata
Class: Mammalia
Order: Rodentia
Suborder: Sciuromorpha
Family: Sciuridae
Genus: Sciurus
Subgenus: Sciurus
Species: S. carolinensis
Could benefit from seeds and foliage to eat.
Blue Jay
Kingdom: Animalia
Phylum: Chordata
Class: Aves
Order: Passeriformes
Family: Corvidae
Genus: Cyanocitta
Species: C. cristata
Could benefit from invertebrates and seeds to eat and bushes to make nests in or to take supplies from to build nest elsewhere.
House Sparrow
Kingdom: Animalia
Phylum: Chordata
Class: Aves
Order: Passeriformes
Superfamily: Passeroidea
Family: Passeridae
Genus: Passer
Species: P. domesticus
Could benefit from invertebrates and seeds to eat and bushes to make nests in or to take supplies from to build nest elsewhere.
We hope to repeat the experiment and get more fruitful results in the future so that we can collect actual data and report it. We did, however, address the question by viewing sample organisms of each from the Berlese funnels of our classmates. We were able to differentiate between coelomates, pseudocoelomates, and acoelomates now based on some of their morphological and locomotive features.
-AW
2/17/14
Lab 4
In this lab, we tried to identify plants in our transect and categorize them based on morphological traits such as vascularization, leaf structure, stem structure, and seed/flower production.
After separating the parts of our plants and recording their immediate differences, we recorded the more detailed differences and characterizations of the plant samples from our transect.
The vascularization of plants 1, 2, and 4 are monocot and have phloems dispersed randomly inside of the stalk of the plant.
The leaves of plants 1, 2, and 4 had straight vein systems throughout, supporting their being monocots.
The vascularization of plants 3 and 5 are dicot and have phloems dispersed in rings around the core of the inside of the stalk of the plant.
The leaves of plants 3 and 5 had a complicated vein system throughout, supporting their being dicots.
Fungi sporangia are sacs where spores grow on fungi. The spores are released from the sporangium and cause the bacteria to spread. These spores allow fungi to reproduce asexually, which is important to the survival of the fungi and its ability to spread under unideal conditions.
This sample is a large, white, circular organism. It appears to have layers and looks fuzzy on top. It also has a ring underneath it that looks as though it is ingrown and inside of the agar as opposed to on top of it. I think that this organism is a fungus and belongs to the ascomycota group, as it looks like a mold. I think that it is a fungus for the following reasons:
-does not appear to have chlorophyll and thus should not be able to be capable of photosynthesis
-has a rigid structure that gives it a fuzzy, raised-bump shape, meaning that it should have a strong, peptidoglycan-filled cell wall
-observable hyphae below and around organism
These are all characteristics of fungi, which leads me to believe that this sample is a fungus.
We were able to identify a diverse range of plant life in our transect. We can now differentiate between monocot and dicot, vascular and nonvascular, and seeding and flowering plants.
-AW
2/7/14
Lab 3
This week we identified bacteria and colonies that grew on our agar petri dishes to further investigate and identify the microbial life in our transect. These bacteria came from our hay infusion cultures. Our culture's volume of water dropped and the water seemed to be murkier and greener. The smell stayed the same. The appearance of the culture might change week to week because of the decreasing water level, creating a more hostile and competitive environment for the bacteria to live in as they fight for space and food. Thus some bacteria will outmatch others, changing the appearance and smell of the culture based on the characteristics of the victorious bacteria.
Looking at the colonies that grew on the plates without the antibiotic and the plates with the antibiotic, the most prevalent difference is that there are far fewer colonies, if any at all, on the antibiotic plates. I think this means that the antibiotic worked and killed most or all of the bacteria on the antibiotic plates. The only plate that showed any growth was the 10^-3 plate, which only had 7 colonies, while the 10^-3 plate without antibiotics was covered in a lawn. The tetracycline killed most, if not all, of the bacteria, and I believe that what was left was fungi, as these colonies looked less like a bacterial colony and more like a mold. None of the bacteria were unaffected by the tetracycline. Tetracycline, which works by stopping protein synthesis in bacterial cells, is usually a very reliable antibiotic, but some streptococcus and staphylococcus strains have an inherent resistance.
The three agar petri dishes we chose to sample were the 10^-3 with tetracycline, 10^-5 without tetracycline, and 10^-7 without tetracycline. Here are the morphologies of the colonies we sampled:
10^-3 with tetracycline: The individuals in this colony were rod shaped and lined up in a chain, making them streptobacilli. The colony itself was circular and convex and had a yellow/orange color. They turned out to be Gram positive after staining them, so they probably had a thick peptidoglycan layer in their cell walls. They were not motile.
10^-5 without tetracycline: The individuals in this colony were circular and lined up in a long chain as well, making them streptococcus. The colony itself was circular and convex as well and was a bright yellow color. They turned out to be Gram positive after staining them, so they probably had a thick peptidoglycan layer in their cell walls. They were not motile.
10^-7 without tetracycline: The individuals in this colony were circular and grouped in bunches, making it staphylococcus. The colony itself was circular and umbonate and transparent with a beige tint. They turned out to be Gram negative after staining them, so they probably had a thin peptidoglycan cell wall. They were not motile.
We were able to successfully identify different types of bacteria in our transects after this lab. While not encompassing all forms of microbial life, we now have a better understanding of what microbial life looks like and how diverse it is in our transect. We also learned how to grow this bacteria and collect it, important tools that will help us down the road in our science careers.
-AW
1/23/14
Lab 2
We are making observations about our hay infusion cultures in order to see what different types of bacteria and protists might grow in different parts of the culture. Our culture was murky and brown/green. All objects in the culture were covered in bacteria, giving them a fuzzy appearance. There was a thin, moldy film on top of the water. The culture gave off a smell that was similar to body odor. The two niches we observed were from the very top of the culture (the film laying on the surface) and the bottom of the culture (among the gunk that settled on the bottom). There was a leaf on the bottom of the culture that we took the bottom-niche sample from. There were probably more bacteria surrounding the leaf as it would have provided them with nutrients in the culture. I have attached a picture of the 6 organisms (3 from each niche) below, and I will describe them as well. The numbers in the descriptions of the organisms correspond to the numbers written next to them on the picture.
File:6 Organisms from Hay Infusion Culture.png
Organisms from the top of the culture:
1. I think that this organism is the protist paramecium bursaria. The observed organism was elongated, clear, motile organism covered in cilia. It did not appear to photosynthesize. It is 50 micrometers, which is close to that of paramecium bursaria.
2. I think that this organism is the protist vorticella. The observed organism had a flower-like shape, with a large head connected to a long flagella-like appendage and was clear throughout. There were cilia that protruded from the top of the head. It is motile, in a way, as the long flagella would wind up and spring out suddenly, moving the head from one place to another. It was 25 micrometers, which falls between the 15-50 micrometer size of a vorticella. The shape is also almost identical to that of vorticella.
3. I think that this organism is the protist chlamydomonas. The observed specimen was a circular, immobile, single celled organism with two flagella. It is also green, which leads me to believe that it photosynthesizes. It was 10 micrometers, which falls between the 5-12 micrometer size of a chlamydomonas.
Organisms from the bottom of the culture:
4. I think that this organism is the protist colpidium sp. The observed specimen was clear, motile, covered in cilia, and had an ovular shape. It was 45 micrometers, which is close to the 50-70 micrometer range of "colpidium" sp.
5. I think that this organism is the protist bursaria truncatella. The observed specimen was large, clear, covered in cilia, motile, and did not have a distinct, constant shape. It also had many nuclei. It was 400 micrometers, which is close to the 500-1000 micrometer range of "bursaria truncatella".
6. I think that this organism is the protist paramecium aurelia. The observed specimen had an elongated oval shape that was tapered to a point at one end. It was clear, motile, covered in cilia. It was 100 micrometers, which is close to the 120-180 micrometer range of "paramecium aurelia".
Different types of bacteria were found in the different niches within the culture. If my identifications are accurate, then there were six completely different types of bacteria throughout the culture (3 in from the top layer and 3 from the bottom). This shows great diversity in our culture and how even small parts of a niche (our transect) can hold a variety of life.
I think that vorticella meets all of the needs for life. It uses energy, as exemplified by its coiling its flagella like a spring to propel it. It is a protist, which means two things: it has cells and DNA, fulfilling the necessities for living organisms to be made of cells and to have hereditary information that is able to be passed on. While I am not positive, I assume it can reproduce in some way, as most protists can, fulfilling one for requirement for life. Lastly, it can adapt to its environment, or evolve, because its DNA can become randomly mutated which may or may not give rise to a beneficial trait, fulfilling the last need for life.
If the hay infusion culture had been observed for two more months, we would have seen a significant increase in bacteria growth, but this would eventually stop at some point, when the environment met its carrying capacity. If we left it for two more months, we would also likely see a drop in the water level as it evaporates over time. Future studies could include seeing how the population size and carrying capacity is affected as the culture is left to stagnate and change.
Some selective pressures of the environment that might have affected the composition of my samples could have been food availability (dried milk, leaves, grass, etc.), environment size (the jar can only hold so many organisms), and oxygen/carbon dioxide availability (the film on top may have prevented these gasses from getting to the bacteria that might need it for respiration or photosynthesis).
File:Serial Dilution Drawing.png
We were able to successfully identify many types of protists from this lab. We also began to grow bacteria to help us understand the diverse bacterial life in our transect. The protists alone were extremely diverse, ranging in size, shape, color, body structure, and locomotion.
-AW
1/16/14
Lab 1
In this lab we tried to identify the basic layout of our transect and see what type of ecological system it might be. We did this by making general observations about the vegetation life, animal life, and other biotic factors in addition to abiotic factors.
Our transect is directly in front of the Kogod School of Business, between it and Massacusetts Ave. Most of the ground is dirt, but part of the lawn runs through the transect as well. On the dirt section, there are five large rocks/stone slabs. In the middle of these five stones is a group of willows. Next to the grassy part of the transect, right where the dirt meets the grass, there are two red bushes. Some biotic factors of the transect include grass, bushes, willows, seed pods, and leaves (most of which were dead). Some abiotic factors of the transect include rocks, stone slabs, cinderblock, dirt, and gravel.
By the end of the lab, we were able to identify many aspects of the transect. After investigation, we can comfortably call it a small marsh or prairie type ecological system. However, it is mostly manmade because it is part of a scenic college campus, and so it is difficult to put it in only once category or another, as it does not technically fit in any. But we were able to find its closest match, which is a prairie or small marsh.
-AW